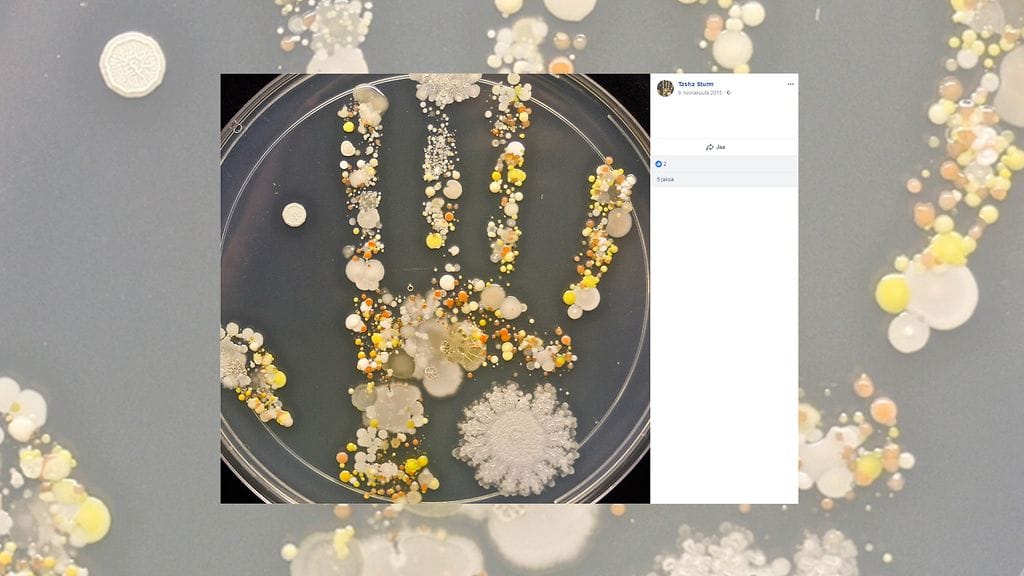

Äiti pyysi 8-vuotiasta poikaansa koskettamaan petrimaljaa kämmenellään. Viikossa maljaan oli kasvanut kämmenen muotoinen bakteeriviljelmä.
Yllä oleva video opettaa, miten kädet pestään oikein!
Amerikkalainen laboratoriossa työskentelevä Tasha Sturm oli tottunut siihen, että opiskelijat ottavat bakteerinäytteitä kaikenlaisista esineistä. Vuonna 2015 Sturm päätti tehdä oman testinsä: pani lapsensa leikkimään ulkona ja silittelemään perheen koiraa.
Kun poika palasi sisään, Sturm pani hänet koskemaan petrimaljaa kämmenellään.
Jos kuva ei näy, katso se täällä.
Viikossa maljaan kasvoi bakteeriviljelmä
Viikossa maljaan oli kasvanut kämmenen muotoinen bakteeriviljelmä. Kuva kämmenestä on nyt lähtenyt nyt kevään korvilla uuteen kiertoon.
Kuvassa olevat bakteerit ovat täysin normaaleja, ja niitä löytyy esimerkiksi ulkoa maasta. Terveyden kannalta on tärkeää olla tekemisissä bakteerien kanssa.
– Oppi, jonka tästä voi saada, on, että jotta omaisit terveen immuunipuolustuksen, sinun täytyy altistua kaikenlaisille asioille, Sturm kommentoi lle vuonna 2015 ja muistutti, että iho suojaa ihmistä monilta taudinaiheuttajilta.